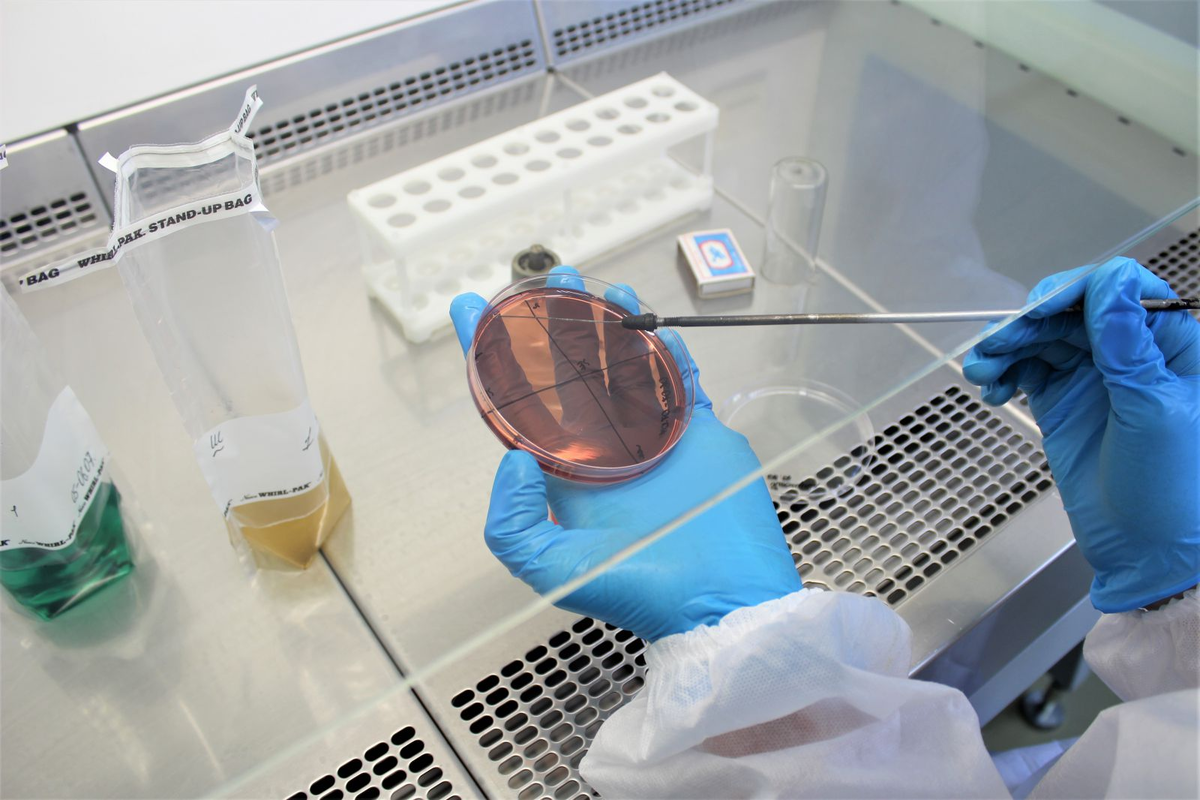
лАБОРАТОРИЯ

- Самара, ул. Арцыбушевская 175
- 8(937)208-90-22

® БАЛУ ветклиника - зарегистрированный товарный знак
ВЕТЕРИНАРНАЯ КЛИНИКА В САМАРЕ
С заботой о ваших питомцах

НЕСКОЛЬКО СЛОВ О НАШЕЙ КЛИНИКЕ
Ветеринарная клиника «Балу» ― это высокий профессионализм персонала, внимательное отношение к животным, самые современные методики и демократичная ценовая политика.
Персонал клиники, имея высокую квалификацию, большой опыт работы и современное оборудование, позволяет оказывать помощь питомцам на максимально высоком уровне.
Наша главная задача - качественная ветеринарная помощь
цепов михаил владимирович
руководитель и ГЛАВНЫЙ ВРАЧ КЛИНИКИ
Окончил Сергиевский ветеринарный техникум в 2007 году, Самарскую государственную сельско-хозяйственную академию в 2012 году. Стаж работы с 2007 года. Постоянно принимает участие в мастер классах, семинарах, конференциях по ветеринарии.

НОВОСТИ КЛИНИКИ
ПОЧЕМУ МОЖНО
Доверить ВАШЕГО ПИТОМЦА нам

У нас работают только опытные врачи-ветеринары

Удобное местоположение в центре города

Заботливое отношение к вашим питомцам

У нас приемлемые цены на все услуги

Современное профессиональное оборудование

Проходим курсы повышения квалификации и совершенствуемся
МЫ ОКАЗЫВАЕМ
Следующие ветеринарные услуги
Терапевтические услуги
от 900 руб
Консультация врача включает в себя проведение осмотра, сбор анамнеза болезни и постановку предварительного диагноза. Для оказания помощи пациенту требуется назначение комплексной диагностики (лабораторные анализы и инструментальное обследование)
Вакцинация
ОТ 1200 РУБ
Вакцинирование животных – это профилактическое мероприятие, направленное на создание у питомцев активного иммунитета. Без вакцинации животному очень опасно гулять на улице, потому что высок риск подхватить заболевания от других животных. Также непривитых животных не пускают в другие страны и даже на борт самолёта
УЗИ
от 800 руб
Ультразвуковое исследование на сегодняшний день является самым доступным видом диагностических инструментальных процедур, одним из самых надежных и необходимых методов постановки диагноза. УЗИ позволяет ветеринарным врачам вовремя назначить лечение и тем самым помочь пациенту. В нашей клинике имеется современный аппарат УЗИ
Стерилизация
от 4000 руб
Кастрация кота или кошки – одна из самых частых операций животных, которые живут в городских квартирах. Она представляет собой удаление половых желез у питомца путем хирургического вмешательства. У самцов вырезают семенники, у самок – яичники. Кастрация достаточно простая операция, и если она сделана профессионалом, то риски для питомца минимальны. И все же от хозяина требуется некоторая подготовка
Санация ротовой полости
от 2500 руб
Санация ротовой полости – это комплекс оздоровительных мероприятий, включающих в себя удаление разрушенных зубов и корней, снятие зубных отложений и бляшек, лечение десен и обработка ротовой полости антисептическими препаратами. Санация ротовой полости может быть плановой и внеплановой, когда на приеме у ветеринарного врача обнаруживаются патологии ротовой полости и зубов
реанимация животного
от 3000 руб.
Экстренная реанимация животного - это комплекс мероприятий направленных на восстановление жизненных функций организма. Различают сердечно-легочную, сердечную, дыхательную реанимацию
СТОИМОСТЬ УСЛУГ
| Наименование услуги | Цена |
| Первичный прием с постановкой предварительного диагноза | 900 руб |
| Повторный прием | 450 руб |
| Установка в/в катетера (стоимость катетера включена) | 400 руб |
| П/к или в/м инъекция (без стоимости препарата) | 150 руб |
| Забор крови на анализ (стоимость анализа не включена) | 200 руб |
| Вакцинация отечественной вакциной | от 1200 руб |
| Вакцинация импортной вакциной | от 3000 руб |
| Первичное УЗИ брюшной полости | от 1300 руб |
| Первичное УЗИ мочеполовой системы | от 700 руб |
| Первичное УЗИ на беременность | от 800 руб |
| Повторное УЗИ брюшной полости в процессе лечения | от 800 руб |
| Повторное УЗИ мочеполовой системы в процессе лечения | от 400 руб |
| Кастрация кота | 2000 руб |
| Кастрация кобеля, цена зависит от веса | от 3500 руб |
| Кастрация кошки, цена не включает в себя послеоперационную попону и повторный осмотр | от 4000 руб |
| Кастрация суки, цена зависит от веса | от 5000 руб |
| Санация ротовой полости ультразвуком (в зависимости от веса животного рассчитывается доза наркоза) | от 2500 руб |
| Экстренная реанимация животного, цена зависит от веса животного и использованных препаратов | от 3000 руб |
ЗАДАЙТЕ ВОПРОС СПЕЦИАЛИСТУ
ОТВЕТЫ СПЕЦИАЛИСТОВ
НА ЧАСТЫЕ ВОПРОСЫ КЛИЕНТОВ
В каком возрасте проводить стерилизацию?
Как готовиться к операции?
Что такое пироплазмоз или бабезиоз собак?
Как уберечь свое животное от бабезиоза?
Что такое мочекаменная болезнь?
Какими являются основные симптомы заболевания?
Что такое ультразвуковая чистка зубов?
РЕАЛЬНЫЕ ОТЗЫВЫ НАШИХ КЛИЕНТОВ
Прочитать все отзывы и оставить свой вы также можете в отметке нашей компании на Яндекс Картах по этой ссылке
ПОДРОБНАЯ ИНФОРМАЦИЯ
Об особенностях болезней и лечения
КОНТАКТЫ
Мы ждем вас по адресу
г. Самара, ул. Арцыбушевская 175, вход с торца, за "Октопусом"
Звоните по телефону
График работы
Пн - Вс с 10.00 до 21.00
Пишите в мессенджеры